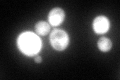
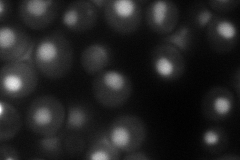
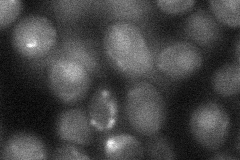
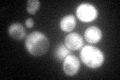
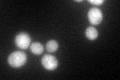

View description
Protein required for respiratory growth; localized to both the nucleus and mitochondrion; may interact with transcription factors to mediate the transition to respiratory growth and activate transcription of nuclear and mitochondrial genes
Localization:
Intensity:
Fold change:
Significance:
-
C’ GFP library in SD
cytosol138.9 -
N' NOP1pr-GFP in SD

nucleus62.4317 -
N' TEF2pr-mCherry in SD
nucleus86.9742 -
N' NATIVEpr-GFP in SD

nucleus22.6383 -
N' TEF2pr-VC and Cyto-VN in SD
below threshold28.9834 -
C’ GFP library in SD+DTT

cytosol94.010.67No -
C’ GFP library in SD+H2O2
cytosol149.871.07No -
C’ GFP library in Starvation Media
cytosol177.531.27No -
C’ GFP library on the background of Pup2-DaMP

cytosol -
C’ GFP library on the background of CCT mutant

cytosol146.9421.05782No
